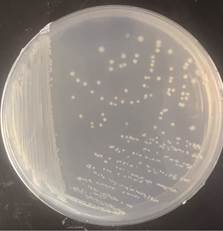

常春藤叶际Priestia flexa的分离、鉴定及氮氧化物转化特性
(1. 中国科学院生态环境研究中心, 北京 100085
2. 中国科学院大学中丹学院, 北京 100049
3. 中国科学院大学资源与环境学院, 北京 101314
4. 郑州大学河南先进技术研究院, 郑州 450001
5. 中国地质大学 (北京) , 北京 100083)
摘要: 【背景】氮氧化物 (NOX) 是我国优先控制的主要空气污染物之一, 而植物在清除空气中氮氧化物方面具有重要贡献。植物叶际微生物能否提高空气中氮氧化物的清除效率仍是待解之谜, 因此, 分离筛选高效转化空气中氮氧化物的叶际微生物至关重要。【方法】本研究采用氮氧化物选择性富集培养的方法, 从常春藤叶际微生物培养物中分离筛选获得一株高效转化氮氧化物的功能菌株, 编号LZY1。通过16S rRNA基因测序、生理生化鉴定, 确定菌株的分类, 并优化其生长条件(温度、pH) , 测试其对氮氧化物的转化能力。此外, 采用烟雾箱实验, 验证该菌株对空气中氮氧化物的消减效果。【结果】研究结果表明, 菌株LZY1能够以二氧化氮 (NO2) 为唯一氮源生长。16S rRNA基因测序结果显示, 该菌株与弯曲普里斯特氏菌 (Priestia flexa) 亲缘关系最近 (相似性100%) ; 该菌株孢囊未膨大, 具有硝酸盐还原、催化酶活性、运动能力、柠檬酸盐利用和明胶液化能力, 但不进行VP反应 (Voges-Proskauer test) , 且不具备厌氧生长能力, 与Priestia flexa的代谢特性一致。菌株LZY1的适宜生长条件为30℃、pH4. 0~6. 0, 并能在较宽的pH范围 (4. 0~9. 0) 内生长。烟雾箱实验结果表明, 该菌株对空气中氮氧化物的消减速率显著高于对照组, 能够较快降低空气中NO2的浓度。【结论】从植物叶际分离筛选的LZY1菌株为Priestia flexa, 具有高效转化空气中氮氧化物的特性, 对环境的适应能力较强。研究结果为氮氧化物污染空气的生物修复提供了参考, 为大气污染治理提供了新思路。
关键词: 氮氧化物, 空气污染防治, 叶际微生物, 弯曲普里斯特氏菌, 生物修复
DOI: 10.48014/pceep.20250224003
引用格式: 刘子嫣, 闫高俊, 乔翅嵩, 等. 常春藤叶际Priestia flexa的分离、鉴定及氮氧化物转化特性[J]. 中国生态环境保护进展, 2025, 3(2): 12-24.
文章类型: 研究性论文
收稿日期: 2025-02-24
接收日期: 2025-03-08
出版日期: 2025-06-28
1 引言
氮氧化物(NOX)是一类重要的大气污染物,主要来源于化石燃料燃烧、工业生产及机动车尾气排放,同时也可由雷电、森林火灾和土壤微生物活动等自然过程产生[1,2]。NOX主要包括一氧化氮(NO)和二氧化氮(NO2),其中 NO 在空气中易氧化为NO2,因此NO2被广泛用于环境污染监测和治理研究[3,4]。NOX在大气中可与挥发性有机物(VOCs)发生光化学反应,形成光化学烟雾,加剧空气污染。此外,NOX还可与水分结合生成硝酸(HNO3),导致酸雨污染,从而对土壤、水体和生态系统造成严重破坏[2,5-7]。在人体健康方面,长期暴露于高浓度NOX环境可能引发呼吸系统疾病(如哮喘、支气管炎),增加心血管疾病风险,并可能对神经系统功能产生不良影响[6,8,9]。如何高效降低NOX的环境负荷已成为我国大气污染防治领域的研究重点。
目前,NOX的治理方法主要包括催化还原(SCR)、选择性非催化还原(SNCR)、湿法脱硝和等离子体处理等物理化学手段。其中,SCR技术利用催化剂(如V2O5-WO3/TiO2)在高温条件下还原NOX为N2,而SNCR则通过喷射尿素或氨水,使NOX发生还原反应[10-15]。这些技术虽然能在工业应用中显著减少NOX排放,但往往存在能耗高、催化剂成本昂贵、二次污染等问题。因此,探索更为环保、高效、可持续的NOX处理技术具有重要的现实意义。
近年来,生物修复方法具有环境友好、高效和低成本等优点,逐渐成为NOX污染治理的研究热点[16]。NO2作为大气污染物,能够被植物吸收,并在一定程度上被同化利用,但其影响具有双重性。一方面,NO2可作为氮源促进植物生长,增强硝酸还原酶活性,提高氮素利用率;另一方面,高浓度NO2可能抑制光合作用,影响气孔动态,甚至引起植物的代谢紊乱[17-19]。然而,关于二氧化氮(NO2)对叶际微生物影响的研究较为有限。因此,筛选耐受性强、转化效率高的氮氧化物高效转化菌株,有利于保护植物生理状况,实现NOX污染空气的生物修复。
由植物的叶、茎、花、果等地上有效部分组成的生境统称为叶际,而生存在其表面和内部的大量的各种类型的细菌、丝状真菌、酵母、藻类等微生物则被称为叶际微生物[20]。叶际微生物栖息地的范围广阔:植被模型估计全球叶面积大约是陆地面积的两倍,全球叶际微生物群体中的细菌数量可能达到1026个[21]。近年来,叶际应用微生物学作为一个独特的研究领域,关注基因、基因产物、天然化合物以及支撑叶际特异性适应和功能的性状,这些特性在当前或未来创新中具有商业和经济价值。例如,促进植物生长和抑制病害的叶际细菌、支持人体健康的益生菌及发酵食品,以及可缓解空气污染物、农药残留或塑料污染的微生物等。叶际微生物还能够促进植物生物质转化为堆肥、可再生能源、动物饲料或纤维;它们可生产食品增稠剂和糖替代品、工业级生物表面活性剂、新型抗生素和抗癌药物,以及用作食品添加剂或冷冻剂[22-25]。
本研究采用氮氧化物作为唯一氮源,从常春藤叶际微生物培养物中选择性富集培养高效转化NO2的功能菌株,并对其形态特征、生理生化特性、16S rRNA基因及生长条件进行了系统研究。此外,通过烟雾箱实验进一步评估了该菌株对空气中NO2的消减能力,以期为氮氧化物污染空气的生物修复提供候选菌株。
2 材料与方法
2.1 实验试剂与主要仪器设备
本研究中使用的主要试剂包括硫酸镁、氯化钠、碳酸钙、甘露醇、硫酸钙、磷酸二氢钾(分析纯)等,所有试剂均为分析纯级别,确保实验结果的准确性。所有试剂均由阿拉丁试剂(上海)有限公司(中国)提供。此外,粉末状活性炭和二氧化氮气体则由顺华气体(济宁)有限公司(中国)供应。
研究中使用的微生物培养基包含Luria-Bertani(LB)培养基[33]和无氮培养基,固体无氮培养基(15.6g/L)主要由甘露醇(15.0g/L)、CaCl2·2H2O(0.2g/L)、K2HPO4(0.2g/L)、MgSO4·7H2O(0.2g/L)、MoO3(0.001g/L)和FeCl3(0.005g/L)组成,pH调节至7.2±0.2(25℃)。
实验中使用的主要仪器设备包括:紫外可见分光光度计(DR6000,哈希公司)、小型离心机(EPPENDORF 5430 R)、气相色谱-质谱联用仪(GC-MS,型号QP2010,岛津仪器有限公司)、酶标仪(ELX800,BIOTEK公司)、旋涡混合器(QL-901,上海门其林贝尔仪器制造有限公司,中国)、粉碎研磨仪(TL-48R,上海万柏生物科技有限公司,中国)和研磨仪(FASTPREP-24 5G,MP公司,美国)。此外,痕量级氮氧化物分析仪(E11)由北京是卓科技有限公司(中国)提供。
2.2 叶片采样及叶际微生物洗脱
所使用的植物采购于河北省雄安新区的花卉市场。进行实验前,植物在实验温室中盆栽培养至少7天。植物种植在圆柱形花盆中(直径:15cm,盆高:20cm)。均匀采集中部成熟叶片,并在阳面与阴面随机取样。采样时间于上午07:00—10:00之间进行,采样时间控制在30min之内。采样数量为每株随机取5~10片,采样全程佩戴无菌手套,使用无菌镊子或剪刀,避免交叉污染,并将样本存于无菌取样袋中,迅速冷藏至4℃冰箱[26]。
叶际微生物提取前,人工分拣出不完整或枯萎的叶片,在无菌环境下充分混合后等分成3个平行样品(重约50g)。每个平行样品与500mL无菌PBS缓冲液(磷酸盐缓冲液,pH7.4,1×)混合,依序进行12min超声处理(40kHz)、20min震荡(30℃,180r·min-1)、3min超声处理(40kHz)得到洗脱液[27]。
2.3 氮氧化物转化菌的筛选
考虑到二氧化氮的易挥发性及其与水之间的反应,本研究选择了粉末状活性炭作为吸附剂。首先,将活性炭加热至 300~500℃ 进行灭菌处理,热处理不仅去除了吸附剂中的杂质,还增强了其吸附能力。接下来,将吸附了氮氧化物的粉末状活性炭(2 g/L)加入无氮液体培养基[28,29]中,并充分混合。随后,将无氮培养基加热至 100℃,确保培养基成分完全溶解。在培养基冷却至45~50℃ 时,加入粉末状活性炭,继续搅拌,确保其均匀分布。将均匀混合的培养基倒入培养皿中,待其冷却并凝固,形成固体培养基。将已固化的培养基置于小型二氧化氮暴露箱中进行暴露,期间实时监测箱内二氧化氮浓度,直至其达到稳定状态,表明二氧化氮已被充分吸附,完成对培养基的处理。此时,固体培养基制作已完成。
之后,使用无菌接种环取常春藤叶际微生物洗脱液(106~108 CFU/mL),采用涂布接种法将菌液均匀涂布在培养基表面,确保菌液广泛均匀覆盖。最后,将接种后的培养皿放入培养箱中至菌种数目稳定(温度25℃,相对湿度70%),模拟微生物的生长环境。定期观察菌落的生长情况,包括菌落的形态、大小、颜色等特征,并记录生长过程[30]。
2.4 氮氧化物转化菌的鉴定
2.4.1 16S rRNA基因测序
16SrRNA基因测序是微生物分类和鉴定的关键技术之一[31,32]。本研究使用FastDNASpin Kit for Soil提取DNA,并采用细菌通用引物扩增16SrRNA基因,正向引物8F(5'-AGAGTTTGATCCTGGCTC-3')和反向引物1492R(5'-GGTTACCTTGTTACGACTT-3')。PCR反应体系(50μL总体积)包括1×反应缓冲液(含Mg2+)、200μM dNTPs、0.2μM正向和反向引物、适量模板DNA以及1.25 U Taq DNA聚合酶,并用超纯水补足至50μL。PCR扩增程序如下:首先在94℃预变性5min,随后进行30个循环,每个循环包括94℃变性30s、60℃退火30s和72℃延伸2min,最终在72℃延伸10min以确保扩增完全[33]。
PCR产物经克隆后送上海美吉生物医药科技有限公司完成测序[34]。测序结果得到16S rRNA基因序列,经过NCBI网站的BLAST进行比对,查找与目标菌株序列具有高度同源性的微生物。随后,使用MEGA7软件进行系统发育分析[35],整合目标菌株与同源菌株的16S rDNA序列,采用邻接法(neighbor-joining,NJ)构建氮氧化物转化菌株的系统发育树[36-38]。
2.4.2 生理生化鉴定
(1)革兰氏染色试验[37-38]
将平板培养的菌株进行革兰氏染色,金黄色葡萄球菌做阳性对照,大肠杆菌做阴性对照。染色步骤为:①涂布,风干,固定;②结晶紫染色l min,水洗;③碘液作用1min,水洗;④乙醇脱色20~30s,水洗;⑤番红液染2~3min,水洗;⑥风干后,油镜镜检。
(2)生理生化指标试验[30,41-43]
本研究采用了多种生理生化试验对菌株进行鉴定。在氧化酶试验中,将48h培养的斜面菌种用接种环挑取少量涂于氧化酶试纸上,若试纸在10s内显现红色,则该菌株为氧化酶阳性;接触酶试验通过用灭菌接种环取菌种涂抹于玻片上,加入3%过氧化氢(H2O2),若产生气泡则为阳性,反之为阴性;乙醇过氧化试验中,菌种转接到平板培养基上培养2~3天,观察菌落周围是否形成透明圈,继续培养并观察是否有乳白色晕圈形成,若有,则表明菌株具有乙醇过氧化作用;在甘油生酮试验中,菌种接种于生酮培养基中,在30℃下培养3天,随后加入斐林溶液,若菌落周围出现红色沉淀则为阳性反应;产酸定性试验中,菌种接种于液体培养基中培养2~3天,离心后取上清液,用1mol/L NaOH中和至pH=7,再加热煮沸并滴加5滴5%的FeCl3溶液,若形成红褐色沉淀,则表明该菌株为乙酸菌。这些生理生化试验验证了菌株的代谢特性和生理功能。
碳源利用培养基中的单一碳源共有12种,如下:单糖:葡萄糖、D-核糖、L-鼠李糖、D-木糖、D-甘露糖;寡糖:蔗糖、麦芽糖、D-海藻糖、乳糖;多糖:淀粉、柠檬酸、甘油;氮源利用培养基中的单一氮源共有7种分别为L-组氨酸、L-亮氨酸、L-天冬酰胺、L-丙氨酸、L-酪氨酸、L-胱氨酸、L-谷氨酸。
2.5 氮氧化物转化菌的培养条件优化
为研究不同环境因子对氮氧化物转化菌生长的影响并优化其培养条件,本研究选取氮氧化物转化菌平板中的单菌落,接种至叶片浸提液中进行培养,作为种子液。叶片浸提液的制备过程为:将新鲜叶片1.5kg置于2L锥形瓶中,加入30L自来水,在100℃条件下煮沸10min,随后去除叶片,得到浸提液[44]。之后,选用不同温度和pH进行后续的培养实验。
2.5.1 培养温度对筛选菌株生长的影响
将5mL种子液转接到新鲜的50mL叶片浸提液中,在pH7.0条件下,分别置于25℃,30℃,37℃,42℃四种温度下的恒温摇床中,以150r/min的转速进行培养,分别在不同时间点(0,12,18,24,36,48,60,72和96h)取混合均匀的培养液在紫外可见分光光度计下测量菌株的生长量(OD600值),最终确定菌种培养的最适温度。
2.5.2 培养基初试pH对筛选菌株生长的影响
使用HCl和NaOH来调节液体培养基的pH值,培养基溶液pH值分别调整为4.0、5.0、6.0、7.0、8.0、9.0、10.0和11.0,将5mL种子液转接到150mL新鲜的叶片浸提液中,置于培养温度30℃、转速150 r/min的恒温摇床中振荡培养,分别在不同时间点(0,8,28,36,48,60,72,96和120h)取混合均匀的培养液在紫外可见分光光度计下测量菌株的生长量(OD600),最终确定菌株培养的最佳pH。
2.6 氮氧化物转化菌接种剂的制备
将叶片浸提液按100~200mL/瓶的装液量分装入500mL三角瓶中,并在115℃的高压灭菌锅中灭菌10min,然后自然降温至接近室温。在超净工作台中,将斜面保存良好的氮氧化物转化菌株接种到叶片浸提液中,随后放入恒温振荡器中,在30℃和150r/min震荡条件下培养24h,当有效活菌数达到3×109CFU/mL以上时,停止培养,得到氮氧化物转化菌培养液[44]。
最后,在氮氧化物转化菌培养液中,按照体积比加入0.5%甘油和0.2%鼠李糖脂,即得到氮氧化物转化菌接种剂。该接种剂应存放在2~10℃的冷藏箱中,保存备用[45]。
2.7 效果验证试验装置的搭建及验证方法
氮氧化物去除效果验证装置如图1所示,实验装置主体主要由三个部分组成,分别为:由亚克力材料制成的小型圆柱形箱体(直径为30 cm,高度为50 cm),自主研发的三通等量自动化通气装置和小型挥发器。其中的自动化通气装置是由三通道注射泵,流量控速器与定时开关共同组成的定时定量自动通气的装置,更精确地保证每个处理通入等量二氧化氮。挥发器放置在盛装特定菌液的锥形瓶中,可以加速菌液的挥发。
为了验证菌株对氮氧化物的去除效果,本实验设置了五个处理组,包括对照组(CK,含叶片提取液)、氮氧化物转化菌组、灭活氮氧化物转化菌组、枯草芽孢杆菌组和灭活枯草芽孢杆菌组。每个处理组的实验装置中均通入等量的二氧化氮(8.0mg/m3)。
3 结果与讨论
3.1 氮氧化物转化菌的形态特征
本实验分离、筛选得到一株高效的氮氧化物转化菌株,编号为LZY1。该菌株在以氮氧化物作为唯一氮源的培养基中生长最旺盛,表明该菌株对氮氧化物具有较强的耐受及利用能力。

图1 试验装置
Fig.1 Experimental setup
图2 氮氧化物转化菌LZY 1的平板培养
Fig.2 Plate Culture of the Nitrogen Oxide-Converting Strain LZY 1
菌株LZY1在固体培养基上生长时菌落呈白色、圆形、菌落边缘整齐光滑、不易挑起(图2)。在光学显微镜下放大倍数观察,菌株LZY1呈短杆状,长度约为0.6μm,宽度约为0.3μm。
3.2 菌株LZY1的16S rDNA系统发育分析
通过对LZY1的16S rDNA序列在NCBI数据库中进行Blast比对,系统发育树采用邻接法(Neighbor-Joining,NJ)构建,并通过99%及以上的自展值(Bootstrap Value)评估拓扑结构的可靠性(https://en.wikipedia.org/wiki/Priestia_flexa)。同时,将菌株LZY1的16S rRNA基因序列上传至NCBI的GenBank数据库,登录号为PP537588。
从进化关系来看(图3),菌株LZY1(红色标注)与Priestia flexa的聚为同一分支,相似性最高,表明LZY1在系统发育上与Priestia flexa具有密切的亲缘关系。LZY1与Priestia flexa的多个已知菌株(如Priestia flexa AS、IFO15175、OG-3等)聚为一支,并获得了较高的支持率(100%)。LZY1与Bacillus flexa也聚类于同一分支,可能Bacillus flexa是沿用的旧分类名称。因为近年来芽孢杆菌属经历了较大规模的分类学调整,基于基因组分析和系统发育学研究,多个原属于Bacillus的菌株被重新划分为Priestia、Weizmannia、Peribacillus等新属[46,47]。

图3 菌株LZY1的16S rRNA基因系统发育树
Fig.3 Maximum likelihood phylogenetic tree of strain LZY1 based on the 16S rRNA gene sequences
3.3 氮氧化物转化菌的鉴定
3.3.1 生理生化鉴定
根据《常见细菌与古菌系统分类鉴定手册》对弯曲普里斯特氏菌(Priestia flexa)的描述[48],进一步对比所得菌株LZY1与Priestia flexa的生理生化特性,以明确LZY1的代谢能力及其与已知菌株的相似性和差异性。
结果显示(表1),LZY1与Priestia flexa在多项生理生化特性上存在相似性。两者均不具备孢囊膨大能力,且不支持厌氧生长。在革兰氏染色实验中,LZY1为革兰氏阳性菌。同时,两者均具有柠檬酸盐利用和明胶水解能力,而且能够分解明胶中的蛋白质。
但也存在少量差异。在生化测试方面,LZY1对硝酸盐还原呈阳性(+),表明其可能具备硝酸盐还原酶系统,可将硝酸盐转化为亚硝酸盐或氮氧化物,为其在氮循环中的潜在作用提供了证据。而Priestia flexa在此项测试中为阴性(-),表明其缺乏此类代谢途径。此外,LZY1在动力测试中表现出阳性(+),意味着其具有运动能力,而Priestia flexa未报道(NR)。在3%过氧化氢分解试验中,LZY1表现为阳性(+),说明其具备过氧化氢酶活性,可降解H2O2,提高其抗氧化应激能力,而Priestia flexa在此项实验中未报告结果(NR)。
表1 菌株生理生化鉴定结果
Table 1 Physiological and biochemical characteristics of strain LZY1
|
菌种名称 |
Priestia flexa(MK256302) |
LZY1 |
|
孢囊膨大 |
- |
- |
|
厌氧生长 |
- |
- |
|
革兰氏染色 |
|
- |
|
硝酸盐 |
- |
+ |
|
VP |
- |
- |
|
动力 |
NR |
+ |
|
柠檬酸盐 |
+ |
+ |
|
明胶 |
+ |
+ |
|
3%过氧化氢 |
NR |
+ |
总体而言,LZY1在生理生化特性上与Priestia flexa存在较高的相似性,结合16S rDNA测序结果及进化树分析,可以基本判断LZY1菌株属于Priestia flexa。但其在硝酸盐还原、动力性及过氧化氢降解能力上表现出独特的生理特征。这些特性可能为LZY1在氮氧化物降解过程中提供了代谢优势,进一步支持了其在环境修复应用中的潜力。
3.3.2 唯一碳氮源试验
对菌种LZY1,进行唯一碳氮源利用能力的测定,12种碳源和7种氮源利用能力测定结果见表2和表3。从表2结果可得出LZY1菌株能利用葡萄糖、D-核糖、蔗糖、麦芽糖、柠檬酸和甘油为唯一碳源;但是不能将L-鼠李糖、D-甘露糖、乳糖和淀粉作为唯一碳源。从表3可得出LZY1菌株可将L-亮氨酸、L-天冬酰胺、L-酪氨酸、L-胱氨酸当作唯一氮源;但无法利用 L-谷氨酸为唯一氮源。
表2 菌株唯一碳源利用结果
Table 2 Sole carbon source utilization by strain LZY1
|
碳源 |
菌种LZY1 |
|
葡萄糖 |
+ |
|
D-核糖 |
+ |
|
L-鼠李糖 |
- |
|
D-木糖 |
+ |
|
D-甘露糖 |
- |
|
蔗糖 |
+ |
|
麦芽糖 |
+ |
|
D-海藻糖 |
+ |
|
乳糖 |
- |
|
淀粉 |
- |
|
柠檬酸 |
+ |
|
甘油 |
+ |
表3 菌株唯一氮源利用结果
Table 3 Sole nitrogen source utilization by strain LZY1
|
氮源 |
菌种LZY1 |
|
L-组氨酸 |
+ |
|
L-亮氨酸 |
+ |
|
L-天冬酰胺 |
+ |
|
L-丙氨酸 |
+ |
|
L-酪氨酸 |
+ |
|
L-胱氨酸 |
+ |
|
L-谷氨酸 |
- |
3.4 菌株LZY1的培养条件优化
3.4.1 培养温度的条件优化
图4展示了不同温度条件下菌株的生长情况,以OD600值衡量其细胞浓度,绘制生长曲线。结果表明,该菌株在30℃条件下生长最佳,其生长速率最快。在35℃条件下,菌株仍能较好地生长,最终OD600值略低于30℃。而在25℃条件下,菌株的生长速率明显降低,而在40℃条件下,该菌株的OD600值几乎无明显增长,表明该菌株不耐受高温。
从生理机制上理解,该菌在30℃条件下生长最快,可能是因为此温度范围内,其细胞代谢酶活性最强,膜流动性最佳,营养物质吸收效率最高,从而保证了细胞的快速繁殖。而在35℃时,部分酶活性可能受到轻微抑制,导致最终生长量略低于30℃。在25℃环境下,由于较低的温度可能降低了酶促反应速率,使菌株的代谢水平下降,从而生长较慢。而40℃的高温可能诱导热应激反应,抑制菌株的生长。该菌株在25℃至35℃范围内均可稳定生长,表明其具备一定的环境适应能力,为其在实际应用中的可行性提供了支撑。

图4 不同温度条件下菌株LZY1的生长情况(OD600)
Fig.4 Growth of strain Priestia flexa at different temperatures(OD600)
3.4.2 培养pH的条件优化
图5展示了不同pH条件下菌株的生长情况,横坐标表示培养时间(h),纵坐标为 OD600 值,用于表征菌体生长情况。实验结果表明,在 pH为4.0~6.0的培养条件下,菌株的生长速率最快,表明该菌株适宜在偏酸性环境下生长。而在pH为7.0的条件下,菌株的生长速率虽然稍低于pH为4.0~6.0的条件下生长,但仍能保持较高的 OD600 值。相比之下,在pH为8.0和9.0时,菌株的生长受到明显的抑制,这可能与碱性环境对细胞代谢的影响有关,导致菌株长期生长受限。而在pH为10.0和11.0时,菌株的生长受到严重抑制,OD600值始终处于较低水平,表明高pH环境可能抑制了菌体的生理代谢功能。
综合来看,LZY1菌株的适宜生长pH范围为4.0~6.0,并在pH为4.0和9.0范围内都能生长,表明其具有较宽的酸碱环境适应性。

图5 不同pH条件下菌株LZY1的生长情况(OD600)
Fig.5 Growth of strain Priestia flexa underdifferent pH conditions(OD600)
3.5 菌株LZY1在适宜条件下对空气中二氧化氮的消减
图6展示了不同处理条件下NO2浓度随时间的变化情况,以评估不同种类菌株对气态NO2的消减效果。图中包含五种处理组,分别为CK组(对照组,添加等量叶片浸提液)、Priestia flexa组(添加等量具有活性的Priestia flexa LZY1接种剂)、灭活Priestia flexa组(添加等量灭活的Priestia flexa LZY1接种剂)、Bacillus subtilis组(添加等量具有活性的枯草芽孢杆菌接种剂)、灭活Bacillus subtilis组(添加等量灭活的枯草芽孢杆菌接种剂),每个处理组设置三个重复。

图6 菌株LZY1在最适生长条件下对二氧化氮的消减效果曲线
Fig.6 Nitrogen Dioxide reduction curve of strain Priestia flexa under optimal growth conditions
从结果来看,Priestia flexa组表现出最显著的NO2消减能力,在5 min 内其NO2浓度迅速下降,并在30 min 内几乎降至零,表明该菌株能够高效转化NO2。相比之下,Bacillus subtilis组同样具有一定的NO2消减能力,但其下降速率稍低于Priestia flexa,说明Priestia flexa在NO2转化能力方面更具优势。
另一方面,灭活Priestia flexa组和灭活Bacillus subtilis组虽然仍有一定的NO2消减作用,但消减速率远低于对应的活菌组,表明活菌状态对于NO2的高效转化至关重要,而灭活菌体可能主要通过物理吸附和吸收作用降低了NO2浓度。此外,对照组(CK)在整个实验过程中NO2浓度下降最缓慢,表明在无菌条件下,NO2的自然消散速率较低。
综上所述,Priestia flexa LZY1菌株对NO2的去除效率最高,其转化能力依赖于活菌的代谢活动。这一结果为Priestia flexa在氮氧化物污染治理中的应用提供了参考,验证了其在大气NO2消减中的潜在应用价值。
4 结论
本研究通过氮氧化物选择性富集培养的方法,从常春藤叶际微生物群落中筛选获得了一株高效氮氧化物转化菌 LZY1,并对其生理生化特性、系统发育关系及生长条件进行了系统研究。结果表明,该菌株归属于弯曲普里斯特氏菌(Priestia flexa),能够在 NO2 为唯一氮源的条件下生长,并在 pH 为4.0~6.0和 30℃下表现出良好的生长状态。烟雾箱实验结果显示,Priestia flexa LZY1菌剂对空气中的 NO2 具有高效的消减或转化能力。
5 展望
本研究为氮氧化物污染的微生物治理提供了初步的实验数据,筛选出一株高效的氮氧化物转化菌Priestia flexa,并对其生长条件及降解能力进行了系统研究。尽管目前的研究仅限于菌种消减效果离体实验,并且展示了Priestia flexa菌株在单独培养下的良好NO2转化能力,但现实中微生物的降解效果受到多种因素的影响,如环境中的微生物群落互作、物质的竞争利用等。应用一个完整的叶际修复技术,叶际微生物与植物的共培养试验是不可或缺的,因为在自然环境中,微生物往往处于群体环境下,通过共培养,我们可以更好地模拟真实污染情境下的微生物降解过程,因此,共培养实验将是下一步研究的核心,期望形成一个更加高效的植物-叶际微生物协同降解系统。
除了共培养实验,我们还计划探索基因工程改造和代谢途径优化,通过定向改造菌株,使其在更广泛的环境条件下仍能保持较高的降解能力。通过这种方法,Priestia flexa及其他具有污染物降解能力的叶际微生物菌种可以在实际应用中表现出更强的适应性和更高的降解效率。
总体而言,未来的研究将在叶际微生物群落共培养、基因工程优化和环境适应性研究等多个方面展开,推动叶际微生物修复技术在大气污染,水体污染等领域的实际应用。通过这些研究,我们期望叶际微生物能为未来环境污染的治理提供更加高效、可持续的生物技术方案,最终为环境保护和人类健康贡献力量。
致谢:衷心感谢中国科学院雄安创新研究院呼庆研究员在研究过程中提供的悉心指导和宝贵建议。感谢实验室李瑞、高天明、马超等在实验设计、数据分析和论文撰写过程中给予的帮助。
利益冲突: 作者声明没有利益冲突。
[①] *通讯作者 Corresponding author:白志辉,zhbai@rcees.ac.cn
收稿日期:2025-02-24; 录用日期:2025-03-08; 发表日期:2025-06-28
基金项目:国家自然科学基金项目(42177111,42377126)、中国科学院国际合作伙伴计划(121311KYSB20200017)资助
参考文献(References)
[1] 刘小华. 基于氮氧化物危害及其防治对策[J/OL]. 低碳世界, 2017(09): 8-9.
https://doi.org/10.16844/j.cnki.cn10-1007/tk.2017.09.006.
[2] 王明星, 廖昌建. 化石燃料燃烧过程中氮氧化物排放量的评估[J/OL]. 当代化工, 2011, 40(03): 304-306.
https://doi.org/10.13840/j.cnki.cn21-1457/tq.2011.03.021.
[3] 刘佩琪, 邓志华, 陈奇伯. 城市园林对大气颗粒物的消减与大气中二氧化硫和氮氧化物的浓度变化[J/OL]. 西北林学院学报, 2016, 31(06): 13-18.
https://doi.org/10.3969/j.issn.1001-7461.2016.06.03.
[4] 许立信, 张淑谦, 童忠良. 燃烧与节能技术[M]. 北京: 化学工业出版社, 2018.
[5] 韩继磊. 政府、公众和企业合作治理大气污染物及策略研究[D]. 兰州: 兰州大学, 2024.
[6] KRZESZOWIAK J, STEFANOW D, PAWLAS K. The impact of particulate matter(PM)and nitric oxides(NOx)on human health and an analysis of selected sources accounting for their emission in Poland[J/OL]. Medycyna S'rodowiskowa, 2016, 19(3): 7-15.
https://doi.org/10.19243/2016301.
[7] GUO Y, ZHU L, YE X, et al. Toxicity Impact Assessment of Nitrogen Oxide and Sulfur Dioxide Emissions in China’s Textile Industry With Chemical Footprint Method[J/OL]. AATCC Journal of Research, 2023, 10(4): 232-240.
https://doi.org/10.1177/24723444231161744.
[8] ASHAL I, SUPUNSIRI W Y, ILYAS K, et al. Implications of trimethylamine N-oxide(TMAO)and Betaine in Human Health: Beyond Being Osmoprotective Compounds[J/OL]. Frontiers in Molecular Biosciences, 2022, 9: 964624-964624.
https://doi.org/10.3389/FMOLB.2022.964624.
[9] OLDENKAMP R, ZELM R van, HUIJBREGTS M A J. Valuing the human health damage caused by the fraud of Volkswagen[J/OL]. Environmental Pollution, 2016, 212: 121-127.
https://doi.org/10.1016/j.envpol.2016.01.053.
[10] 贺泓, 翁端, 资新运. 柴油车尾气排放污染控制技术综述[J/OL]. 环境科学, 2007(06): 1169-1177.
https://doi.org/10.13227/j.hjkx.2007.06.001.
[11] 易红宏, 陈亚雄. 氮氧化物废气的治理技术[J/OL]. 环境科学动态, 1998(04): 18-21.
https://doi.org/10.19758/j.cnki.issn1673-288x.1998.04.005.
[12] 孟月东, 钟少锋, 熊新阳. 低温等离子体技术应用研究进展[J]. 物理, 2006(02): 140-146.
[13] 栾志强, 郝郑平, 王喜芹. 工业固定源VOCs治理技术分析评估[J/OL]. 环境科学, 2011, 32(12): 3476-3486.
https://doi.org/10.13227/j.hjkx.2011.12.008.
[14] 杨加强, 梅毅, 王驰, 等. 湿法烟气脱硝技术现状及发展[J/OL]. 化工进展, 2017, 36(02): 695-704.
https://doi.org/10.16085/j.issn.1000-6613.2017.02.041.
[15] 钟秦. 选择性非催化还原法脱除NOx的实验研究[J/OL]. 南京理工大学学报, 2000(01): 68-71.
https://doi.org/10.14177/j.cnki.32-1397n.2000.01.017.
[16] SONG M, SUN B, LI R, et al. Dynamic succession patterns and interactions of phyllospheric microorganisms during NOx exposure[J/OL]. Journal of Hazardous Materials, 2022, 430: 128371-128371.
https://doi.org/10.1016/J.JHAZMAT.2022.128371.
[17] HU Y, FERNANDEZ V. Nitrate transporters in leaves and their potential roles in foliar uptake of nitrogen dioxide[ J]. Frontiers in Plant Science, 2014, 5: 360.
[18] HU Y, BELLALOUI N, TIGABU M, et al. Gaseous NO2 effects on stomatal behavior, photosynthesis and respiration of hybrid poplar leaves[J/OL]. Acta Physiologiae Plantarum, 2015, 37(2): 1-8.
https://doi.org/10.1007/s11738-014-1749-8.
[19] HU Y. Morpho-physiological responses of Populus alba x P , berolinensis leaves to nitrogen dioxide/exogenous nitrogen-or sulfer-containing compounds[D]. Northeast Forestry University, 2016.
[20] 潘建刚, 呼庆, 齐鸿雁, 等. 叶际微生物研究进展[J/OL]. 生态学报, 2011, 31(02): 583-592.
https://doi.org/10.20103/j.stxb.2011.02.032.
[21] VORHOLT JULIA A. Microbial life in the phyllosphere[ J/OL]. Nature reviews. Microbiology, 2012, 10(12): 828-840.
https://doi.org/10.1038/nrmicro2910.
[22] LINDOW STEVEN E, BRANDL MARIA T. Microbiology of the phyllosphere[J/OL]. Applied and environmental microbiology, 2003, 69(4): 1875-1883.
https://doi.org/10.1128/AEM.69.4.1875-1883.2003.
[23] JACOBSEN B J. Phyllosphere Microbiology[J/OL]. Ecology, 2003, 84(5): 1343-1344.
https://www.jstor.org/stable/90021533.
[24] STEVEN E. LINDOW, JOHAN H. J. LEVEAU. Phyllospheremicrobiology[J/OL]. Current Opinion in Biotechnology, 2002, 13(3): 238-243.
https://doi.org/10.1016/S0958-1669(02)00313-0.
[25] RANGEL L I, LEVEAU J H J. Applied microbiologyof the phyllosphere[J/OL]. Applied microbiology andbiotechnology, 2024, 108(1): 211-211.
https://doi.org/10.1007/S00253-024-13042-4.
[26] 周育, 乔雄梧, 王静, 等. 植物叶际微生物提取方法研究[J/OL]. 植物研究, 2006(02): 2233-2237.
[27] BAO L, GU L, SUN B, et al. Seasonal variation of epiphyticbacteria in the phyllosphere of Gingko biloba, Pinusbungeana and Sabina chinensis. [J/OL]. FEMS microbiologyecology, 2020, 96(3).
https://doi.org/10.1093/femsec/fiaa017.
[28] MONICA C, GIJS K J, ROBBERT K, et al. Exploringmicrobial N2O reduction: a continuous enrichment innitrogen free medium. [J/OL]. Environmental microbiologyreports, 2018, 10(1): 102-107.
https://doi.org/10.1111/1758-2229.12615.
[29] MOUSSA S, ISSA W, AGNIESZKA K, et al. Quantificationof diversity sampling bias resulting from riceroot bacterial isolation on popular and nitrogen-free culturemedia using 16S amplicon barcoding. [J/OL]. PloSone, 2023, 18(4): e0279049-e0279049.
https://doi.org/10.1371/JOURNAL.PONE.0279049.
[30] 司春灿, 林英, 殷俊. 一株油脂降解菌的分离筛选及固定化[J/OL]. 微生物学通报, 2025, 52(01): 186-198.
https://doi.org/10.13344/j.microbiol.china.240318.
[31] REYNA E E, MONTOYA H M, ORDOÑEZ Y T, etal. Insights from a Genome-Wide Study of Pantoea agglomeransUADEC20: A Promising Strain for PhosphateSolubilization and Exopolysaccharides Production[J/OL]. Current Issues in Molecular Biology, 2025, 47(1): 56-56.
https://doi.org/10.3390/CIMB47010056.
[32] SREEKALA A G V, SARASWATHY S M, NATHANV K, et al. Genomic and biochemical investigations inthe biomineralizing potential of an isolated marine ureolyticBacillus sp. N9[J/OL]. Science of the Total Environment, 2025, 964: 178591-178591.
https://doi.org/10.1016/J.SCITOTENV.2025.178591.
[33] SCHÖNFELD J, HEUER H, VAN ELSAS J. D, et al. Specific and sensitive detection of Ralstonia solanacearumin soil on the basis of PCR amplification offliC fragments.[J/OL]. Applied and environmental microbiology, 2003, 69(12): 7248-7256.
https://doi.org/10.1128/AEM.69.12.7248-7256.2003.
[34] MARKUS G, B M E R, AHARON O, et al. Status ofthe SeqCode in the International Journal of Systematicand Evolutionary Microbiology[J/OL]. International Journal of Systematic and Evolutionary Microbiology, 2022, 72(12): 005754.
https://doi.org/10.1099/IJSEM.0.005754.
[35] 郑紫云. 北桑寄生产黄酮内生菌的分离、筛选及其生物活性研究[D]. 太原: 山西医科大学, 2022.
[36] 冯思玲. 系统发育树构建方法研究[J/OL]. 信息技术, 2009, 33(06): 38-40+44.
https://doi.org/10.13274/j.cnki.hdzj.2009.06.032.
[37] 张丽娜, 荣昌鹤, 何远, 等. 常用系统发育树构建算法和软件鸟瞰[J/OL]. 动物学研究, 2013, 34(06): 640-650.
https://doi.org/10.11813/j.issn.0254-5853.2013.6.0640.
[38] 张树波, 赖剑煌. 分子系统发育分析的生物信息学方法[J]. 计算机科学, 2010, 37(08): 47-51+66.
[39] 黄元桐, 崔杰. 革兰氏染色三步法与质量控制[J/OL]. 微生物学报, 1996(01): 76-79.
https://doi.org/10.13343/j.cnki.wsxb.1996.01.015.
[40] 谭啸, 章熙东. 革兰氏染色法观察与区分细菌[J]. 生物学教学, 2019, 44(07): 71-72.
[41] CHEN M, LI J, ZHANG L. A novel plastic-degradingbacteria isolated from farmland soil utilizes non-solecarbon sources to enhance the degradation of poly(butyleneadipate-co-terephthalate)[J/OL]. Journal of EnvironmentalChemical Engineering, 2025, 13(2): 115461-115461.
https://doi.org/10.1016/J.JECE.2025.115461.
[42] 刘效毅, 郭坤亮, 辛玉华. 高温大曲中微生物的分离与鉴定[J/OL]. 酿酒科技, 2012(06): 52-55.
https://doi.org/10.13746/j.njkj.2012.06.045.
[43] 周桂莲, 杨慧霞. 小麦抗旱性鉴定的生理生化指标及其分析评价[J]. 干旱地区农业研究, 1996(02): 65-71.
[44] 中国科学院生态环境研究中心. 一种叶际微生物与植物协同净化空气中臭氧的方法: CN202310233588. 4[P]. 2023-08-25.
[45] 中国科学院生态环境研究中心. 植物与叶际微生物协同消减空气氨污染的方法: CN202310213009. X[P]. 2023-07-11.
[46] GUPTA R S, PATEL S, SAINI N, et al. Robust demarcationof 17 distinct Bacillus species clades, proposedas novel Bacillaceae genera, by phylogenomics and comparativegenomic analyses[J/OL]. International Journalof Systematic and Evolutionary Microbiology, 2020, 70(11): 5753-5798.
https://doi.org/10.1099/ijsem.0.004475.
[47] SUDIP PATEL, RADHEY S. GUPTA. A phylogenomicand comparative genomic framework for resolvingthe polyphyly of the genus Bacillus[J/OL]. Internationaljournal of systematic and evolutionary microbiology, 2020, 70(1): 406-438.
https://doi.org/10.1099/ijsem.0.003775.
[48] 东秀珠, 周宇光, 朱红惠, 等. 常见细菌与古菌系统分类鉴定手册[M]. 北京: 科学出版社, 2023: 144.
Isolation,Identification,and Nitrogen Oxide Conversion Capacity of Priestia flexa from the Phyllosphere of Hedera helix
(1. Research Center for Eco-Environmental Science, Chinese Academy of Sciences, Beijing 100085, China
2. Sino-Danish College, University of Chinese Academy of Sciences, Beijing 100049, China
3. College of Resources and Environment, University of Chinese Academy of Sciences, Beijing, 101314, China
4. Zhengzhou University, Henan Institute of Advanced Technology, Zhengzhou 450001, China
5. China University of Geosciences (Beijing) , Beijing 100083, China)
Abstract: [Background] Nitrogen oxides (NOX) are among the first major air pollutants to be regulated in China, and plants play an important role in their atmospheric NOX removal. However, whether phyllosphere microorganisms can enhance the efficiency of atmospheric NOX removal remains an open question. Therefore, the isolation and screening of phyllosphere microorganisms with high NOX conversion efficiency are of great significance. [Methods] In this study, a nitrogen oxide-selective enrichment culture method was used to isolate and screen a functional strain with high NOX conversion efficiency from the phyllosphere of Hedera helix, designated as strain LZY1. The taxonomic classification of this strain was determined through 16S rRNA gene sequencing and physiological and biochemical identification. Additionally, its growth conditions (temperature, pH) were optimized, and its NOX conversion capacity was assessed. Furthermore, an exposure experiment was conducted to verify the strain’s ability to reduce atmospheric NOX. [Results] The results showed that strain LZY1 could grow using nitrogen dioxide (NO2) as its sole nitrogen source. 16S rRNA gene sequencing revealed that this strain was most closely related to Priestia flexa (100% similarity) . The strain exhibited a colony diameter of
Keywords: Nitrogen oxides, air pollution control, phyllosphere microbiota, Priestia flexa, bioremediation
DOI: 10.48014/pceep.20250224003
Citation: LIU Ziyan, YAN Gaojun, QIAO Chisong, et al. Isolation, identification, and Nitrogen Oxide conversion capacity of Priestia flexa from the phyllosphere of Hedera helix[J]. Progress in Chinese Eco-Environmental Protection, 2025, 3(2): 12-24.